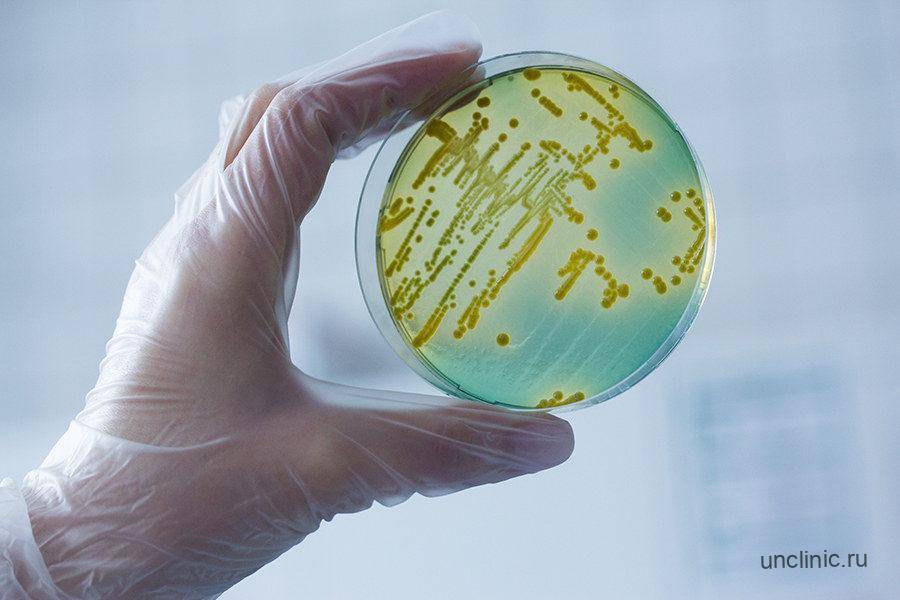

А почему понижена?
Щелочную реакцию мочевой жидкости может вызвать наличие различных причин. Например, резко изменилось питание, при котором происходит сбой регуляции кислотности.
Щелочной баланс мочи может быть низким по таким причинам:
- инфекция, выявленная в мочеполовой системе;
- различные заболевания ЖКТ, надпочечников, щитовидной железы;
- малыш болеет рахитом;
- длительная рвота;
- употребление в пищу только продуктов растительного происхождения, щелочной минеральной водички;
- послеоперационный период.
При пониженном ph мочевой жидкости у человека наблюдается давящая головная боль, слабость, тошнота.

Лечение
Наличие нитритов – только один из симптомов заражения определенными бактериальными инфекциями. Причем эти данные даже не дают возможности узнать, какой именно возбудитель стал причиной недуга. Для постановки диагноза назначают бактериальный посев мочи, УЗИ почек и мочеточника, УЗИ мочевого пузыря и так далее. В соответствии с полученными данными и разрабатывают курс лечения.
Терапия, как правило, предусматривает антибиотики и витаминные комплексы. Препараты назначает только врач. Учитывать следует не только основную болезнь, но и все сопутствующие недуги, возраст пациента, общее состояние.
- Так, при цистите назначают фурагин – используется почти при всех инфекционно-воспалительных недугах выделительной системы, или палин – антибиотик хиноловой группы. Лечение дополняют ибупрофеном, если цистит сопровождается сильными болями, а также фитопрепаратами – цистоном, например.
- Лечение пиелонефрита намного сложнее и требует больше времени. В зависимости от типа возбудителя и чувствительности к тому или иному антибиотику назначают самые разные препараты: от ампициллина – представителя пенициллинов, до тетрациклинов и аминогликозидов – амикацин, например. Как правило, вводят антибиотик внутривенно или внутримышечно. Чтобы улучшить кровообращение в почках, в терапию включают соответствующие медикаменты – курантил, трентал, гепарин. Для обезболивания назначают нестероидные противовоспалительные – лучше всего вольтарен, так как он наименее токсичен.
Лечение может сопровождаться физиологическими процедурами – электрофорезом, парафиновыми аппликациями, диатермией, а также фитотерапией.
Нитриты в моче – признак заболевания, вызванного бактериальными инфекциями. При таких показаниях следует немедленно проводить обследование, даже если внешних симптомов не наблюдается. Обнаружение нитритов при общем анализе мочи и служит поводом для назначения следующих исследований.
Почему возникает кетонурия у детей
Зачастую все объясняется еще несовершенной системой обмена веществ. Причиной кетонурии у детей являются состояния, при которых затрачивается значительное количество энергии. Проявляется обычно при:
- эмоциональных потрясениях;
- повышенных физических нагрузках;
- несбалансированном питании;
- простуде;
Дело в том, что организм ребенка не имеет больших запасов гликогена, поэтому происходит активное расщепление жиров и наблюдаются признаки кетонурии.
Причиной обнаружения ацетона в моче у детей чаще всего становится переутомление, стресс, эмоциональная перегрузка, длительная поездка. Возникает ацидоз и на фоне вирусных, инфекционных заболеваний, кишечных инфекций, особенно если болезнь сопровождается высокой температурой или частой рвотой.
Помимо этого, кетоны в моче у детей до 12 лет указывают на недостаточное поступление жидкости в организм, а также на неправильное и несбалансированное питание.
Временное и незначительное повышение уровня содержания кетоновых тел у детей легко корректируется и чаще всего не является причиной серьезных патологий.
У детей дошкольного возраста кетоны в урине чаще появляются на фоне переутомления или продолжительного стресса. Также спровоцировать такое состояние могут следующие причины:
- эмоциональная нестабильность;
- продолжительная поездка;
- инфекционные заболевания, сопровождающиеся повышением температуры тела и сильной рвотой (особенно кишечные);
- несбалансированное питание;
- снижение иммунитета;
- длительный прием антибиотиков;
- недостаточное поступление жидкости в организм.
Если увеличение уровня кетонов в моче у ребенка незначительно, это чаще всего указывает на отсутствие патологии и быстро поддается корректировке. Но в любом случае при обнаружении компонента требуется провести полноценную диагностику, поскольку присутствие ацетона в урине может быть признаком опасных заболеваний, например, сахарного диабета или дисфункции щитовидной железы.

Стоит учитывать, что большая часть симптомов при кетонурии обычно наблюдается на фоне повышенной температуры тела
Реакция – PH мочи
- Нормальный pH для анализа мочи: кислая реакция. Норма pH мочи: 4.6-8.0
- Ненормальный результат анализа мочи: щелочная моча, слишком низкий или слишком высокий pH мочи.
На что может указывать щелочная моча? Такой результат может указывать, среди прочего, на наличие хронической инфекции мочевыводящих путей. Также щелочная реакция может быть вызвана приемом некоторых лекарств или избытком цитрусовых в рационе.
- Высокий pH мочи может указывать на заболевание почек.
- Низкий pH (кислая моча) может быть результатом тяжелого обезвоживания, диабетических осложнений или недостаточно контролируемого диабета, чрезмерного употребления алкоголя.
Цвет мочи
- Нормальный результат в бланке анализа мочи: чистая моча; желтый / соломенный / янтарный цвет;
- Ненормальный результат анализа мочи: красная моча, кровь в моче, гематурия, темная моча.
Причинами отклонения цвета мочи может быть прием определенных продуктов или лекарств. Красная моча может указывать на гематурию, то есть на наличие эритроцитов в моче. В этом случае чаще всего требуется дополнительная диагностика. Моча темного цвета может указывать на обезвоживание. Любое изменение цвета может указывать на заболевание почек или, например, на неправильно леченный диабет.
Анализ мочи посев
Что означает pH мочи
Мочевыделительная система предназначена не только для освобождения организма от токсичных веществ, но и для поддержания кислотно-щелочного равновесия в теле. Если почки работают нормально, то выделяются равные количества кислых и основных веществ. В этом случае pH мочи считается нейтральной.
Уровень кислотности урины показывает, насколько почки справляются с переработкой минеральных веществ, в том числе магния, натрия и калия. Когда кислотность среды повышена, в организме запускается компенсационный режим. В результате происходит активное расходование минералов. Если вовремя не предпринять меры, со временем изменяется структура костей, появляются отклонения в функционировании внутренних органов.
На уровне ph мочи сказывается рацион человека, образ его жизни, а также пристрастие к вредным привычкам. Важную роль играет состав желудочного сока и правильность протекания обменных процессов в организме.

Нормативные показатели
Норма кислотности урины зависит не только от образа жизни человека, но и от его пола, возраста и веса. Естественными признаются показатели:
- Для грудничков, рожденных недоношенными – от 4,8 до 5,4.
- Здоровые новорожденные, находящиеся на искусственном вскармливании – от 5,4 до 6,9.
- Груднички, питающиеся молоком матери должны иметь кислотность мочи от 5,5 до 6,0.
- У детей до 18 лет неопасным признается интервал значений от 6,9 до 7,8.
- У мужчин со средним весом норма кислотности мочи от 4,6 до 6,5.
- У взрослого представителя сильного пола с избыточной мышечной массой естественным считается показатель от 6,5 до 7,2.
- У женщин нормой кислотности мочи значение должно быть от 6 до 6,5.
- Если дама ожидает рождение ребенка, то естественным считается показатель от 4,5 до 8.
- Кислотность мочи кормящих мам может варьироваться от 6,5 до 7,8.
Показатели ниже нормативных говорят от закислении урины, выше – об ощелачивании. В среднем диапазон значений кислотности от 5 до 7 признается нормальным. Патологией не считаются также небольшие отклонения (в пределах единицы). Чаще они связаны с кратковременным воздействием неблагоприятных факторов.
Как определить pH в домашних условиях?
Измерить состояние кислотно-щелочного баланса сегодня можно даже самостоятельно дома. Для определения pH мочевой жидкости можно использовать:
- лакмусовую бумагу,
- метод Магаршака,
- бромтимоловый синий индикатор,
- индикаторные тест полоски.
Выяснить уровень pH первым методом можно просто поместив в исследуемую жидкость лакмусовую бумагу. Конкретное значение кислотности этот метод не позволяет определить.
Способ Магаршака для определения кислотности мочи – это использование специально приготовленного индикатора на основе двух объемов раствора спирта красного нейтрального с концентрацией 0,1% и одного объёма спиртового раствора синего метиленового с такой же концентрацией. Затем 2 мл мочи смешивают с 1 каплей полученного индикатора. По цвету образовавшейся смеси определяют приблизительное содержание PH.
Бромтимоловый синий индикатор для измерения кислотности готовится путем смешивания 0,1 г растертого индикатора с 20 мл подогретого этилового спирта. Полученную смесь охлаждают, разводят при помощи воды до 100 мл. Затем 3 мл мочи соединяют с каплей индикатора и оценивают результат по полученному цвету.
Перечисленные выше индикаторы требуют некоторых затрат времени. В сравнении с ними более простым и доступным методом измерения pH считаются индикаторные полоски. Этот способ используется как дома, так и во многих лечебно-профилактических центрах. Полоски для определения pH помогают выяснить реакцию мочи в пределах от 5 до 9 единиц.
Однако индикаторные тест-полоски не такие точные, как специальный прибор – иономер.
Анализы мочи для определения беременности
Современные методы лабораторной диагностики позволяют обнаружить факт зачатия ребенка уже на раннем сроке гестации. При этом женщина может провести тест самостоятельно даже в домашних условиях.
Какие показатели учитываются
Существует множество маркеров беременности, однако, используя мочу, можно определять лишь один из них – это бета-хорионический гонадотропин человека (β-ХГЧ). Он принадлежит к группе специфических гормонов периода гестации. Современные тест-системы позволяют фиксировать его наличие в исследуемом биоматериале уже спустя 7-9 дней с момента переноса эмбриона в полость матки.
Определения β-ХГЧ достаточно, чтобы подтвердить факт зачатия ребенка даже на раннем сроке, если период гестации протекает без отклонений. β-ХГЧ может определяться с опозданием при использовании метода ЭКО (экстракорпоральное оплодотворение) и у женщин старше 40 лет. Это значит, что его уровень нарастает медленно – в первые 10 дней с момента переноса эмбриона в полость матки наблюдается отрицательный результат тестов с использованием мочи.
Методы исследования
Чтобы определить наличие беременности, используя мочу женщины, можно применять тесты:
- Качественный. Это подтверждение факта зачатия ребенка с ответом «положительно» или «отрицательно» («да», «нет»). Именно этим вариантом представлено подавляющее большинство тестов, применяющихся для экспресс-диагностики в домашних условиях.
- Полуколичественный, или цифровой. Относительно новый вид тестов, который отражает не только факт беременности при ее наличии, но и приблизительный срок вынашивания плода. Не имеет стопроцентной точности.
Как работает исследование? В контактной области теста находится реактив, который состоит из антител к β-ХГЧ. Если в биоматериале (моче) присутствует этот гормон, они взаимодействуют с ним, что характеризуется изменением цвета диагностической зоны и появлением полосок – одной или двух, в зависимости от выбранной системы.
Качественные тесты классифицируются следующим образом:
| Вид | Способ применения | Особенности | Когда проводить исследование |
|---|---|---|---|
| Полоска | Опустить в материал на несколько секунд | Требуется стерильная емкость, нельзя считывать результат позже заданного в инструкции времени | В утренние часы |
| Планшетный | Капнуть нужное количество мочи в контактную диагностическую зону | Нужна пипетка | |
| Струйный | Пописать на приемный конец | Высокий уровень чувствительности | В любое время суток |
Экспресс-методы можно использовать самостоятельно; планшетные системы применяются в женских консультациях и стационарах, которых принимают беременных пациенток. Они различаются по уровню чувствительности:
- 20-25 мМе/л – определяют факт зачатия лишь с первого дня отсутствия предполагаемой менструации;
- 10 мМе/л – еще до того, как зафиксирована задержка месячных, но не ранее чем через 7-10 дней с момента вероятного наступления беременности.
От вида теста и уровня его чувствительности зависит стоимость.
Важно знать! Количественное определение β-ХГЧ в моче не проводится. Чтобы определить точный уровень гормона, нужно сдавать кровь.
Подготовка к исследованию
Для использования качественных тестов на β-ХГЧ, кроме струйного, нужно:
- Подготовить чистую емкость (сухую, желательно стерильную аптечную).
- Произвести гигиену наружных половых органов и зоны уретры (это желательное требование, так как на реактив не должны попадать фрагменты слизи, фекалий).
- Собрать мочу утром после ночного сна.
- Опустить в материал полоску или использовать пипетку, чтобы набрать нужный объем образца.
Струйные тесты не требуют специальной подготовки и могут проводиться в любое время суток. Лучше выполнять анализ при комнатной температуре. Моча должна быть свежесобранной, без посторонних примесей (слизи, гноя, крови).
Причины изменения общих свойств мочи
Причины изменения общих свойств мочи бывают не только во время болезней, но и во время смены рациона питания или окружающей обстановки. Показатели анализа мочи у детей меняются после долгого нахождения на солнце. Если обнаруживаются нарушения норм, врач назначает дополнительные обследования. Это возможно при патологии печени, болезнях почек, почечной недостаточности, сахарном диабете, мочевыводящих путей, мочевого пузыря или уретры, нарушения обмена веществ, сердечно-сосудистых заболеваний и других патологий. Чтобы не пропустить начавшееся детское заболевание мочевыделительной и других систем, необходимо ежегодно проходить осмотр ребенка у врача, осуществлять исследования крови и мочи. Вовремя выявленная патология и правильное лечение способствуют благоприятному прогнозу.
Может ли анализ мочи показывать беременность?

Зарождение новой жизни в организме женщины не проходит бесследно. Все органы и системы организма будущей мамы перестраиваются для вынашивания ребенка. Это, конечно же, отражается в основных показателях крови и мочи. Многие женщины интересуются, показывает ли анализ мочи беременность? Давайте разбираться.
Анализ на ХГЧ
При помощи стандартных анализов мочи невозможно с точностью диагностировать беременность женщины, особенно на ранних сроках.
Наступившую беременность показывает анализ мочи на ХГЧ. ХГЧ или хорионический гонадотропин человека – это специфический белок-гормон, который вырабатывают оболочки развивающегося эмбриона во время всей беременности. Данный белок необходим для нормального развития беременности.
Благодаря хорионическому гонадотропину в организме будущей мамы блокируются процессы, вызывающие менструацию, и увеличивается продуцирование гормонов, которые нужны для сохранения беременности. Таким образом, повышенное содержание ХГЧ в крови и моче женщины можно назвать одним из самых ранних признаков беременности, который и используется для диагностики.
При нормально развивающейся беременности анализ мочи показывает на пятые–седьмые сутки после зачатия концентрацию ХГЧ более 50 мМЕ/мл. Благодаря этому методу исследования мочи можно установить беременность уже на первой–второй неделе после зачатия.
Для анализа мочи на ХГЧ берут последнюю порцию утренней мочи, которую собирают в чистую посуду. Исследование проводится в течение 25–30 минут. Диагностическая точность данного метода составляет 98%.
Ложноотрицательная реакция
Ложноотрицательная реакция при проведении данного исследования может быть при слишком маленьком сроке беременности, внематочной или нарушенной маточной беременности, некрозе хориальной ткани.
Ложноположительная реакция
Ложноположительная реакция наблюдается при некоторых гинекологических болезнях, опухолях яичника или гипофиза, воспалительных болезнях половых органов, при менопаузе и климактерическом периоде. Прием некоторых лекарственных препаратов (производные фенотиазина, транквилизаторы, алкалоиды) тоже способен вызвать ложноположительную реакцию на ХГЧ.
Принцип действия большинства тестов на беременность также основан на реакции на хорионический гонадотропин человека. Но лабораторное исследование мочи обладает значительно большей точностью, чем тесты на беременность для самостоятельного применения.
Анализ мочи во время беременности
Беременные женщины регулярно сдают общий анализ мочи, в среднем десять раз за весь срок беременности.
Благодаря этому врач постоянно отслеживает состояние здоровья будущей мамы и может своевременно реагировать при выявлении какой-либо патологии.
Существуют нормы показателей анализа мочи у беременных, отклонения от которых могут быть симптомами некоторых заболеваний. Рассмотрим наиболее важные из них.
- Цвет мочи может колебаться от светло-желтого до янтарного. Потемнение мочи может указывать на проблемы с печенью, почками. Но нужно помнить, что существуют некоторые лекарства и продукты (свекла, морковь, ежевика), которые могут менять цвет мочи.
- Прозрачность мочи должна быть абсолютной. Мутная моча, с хлопьями, осадком бывает при развитии воспалительного процесса в организме, повышении уровня фосфатов.
- Плотность или удельный вес в норме должен составлять 1010–1030 г/л. Повышение удельного веса часто является признаком гломерулонефрита (воспаления почек), сахарного диабета, недостатка жидкости в организме. Понижение плотности чаще всего указывает на хроническую почечную недостаточность.
- Кислотность (рН) мочи обычно слабокислая. Если при беременности анализ мочи показывает повышение кислотности, это может быть признаком развития сахарного диабета, почечной недостаточности. Пониженная кислотность мочи сопровождает хронический воспалительный процесс в мочевыводящих путях, может указывать на начало раннего токсикоза.
- Важным показателем анализа мочи у беременных является наличие белка. В моче здорового человека белка быть не должно, или же он не должен превышать 0,033 г/л. При беременности женщины допускается содержание белка в моче не больше 0,075 г/л. Если содержание белка больше этого значения, у будущей мамы существует риск развития позднего токсикоза беременных. Повышение белка после 32-й недели беременности обычно указывает на развитие тяжелого заболевания нефропатии, которое приводит к нарушению функции плаценты. В таком случае женщине необходимо срочное лечение в стационаре или даже стимулирование преждевременных родов.
Определение кислотности мочи в домашних условиях

Определить кислотность мочи можно не только в условиях лаборатории, но и дома. Вариант проведения анализа дома подходит тем пациентам, которые должны самостоятельно отслеживать уровень Ph, из-за наличия сахарного диабета или уратурии.
Часто применяют такие виды исследования как:
- Лакмусовая бумага.
Она пропитана специальным реагентом, который вступает с жидкостью в реакцию, а затем меняет краску. Суть метода сводится к тому, что необходимо опустить сразу два вида полоски синюю и красную в урину и проверить, как меняется оттенок.
Если две полоски остались в том же состоянии, тогда реакция считается нейтральной. Если обе полоски сменили цветовую окраску, тогда принято считать, что в урине есть и щелочная и кислотная реакции.
Если красный цвет сменился синим, тогда присутствует щелочная реакция. При смене синего цвета на красный принято считать реакцию кислотной.
Метод Магаршака.
Суть этого способа определения уровня Ph сводится к тому, что берут два раствора красного и синего цвета, который постепенно добавляют в исследуемый материал.
Далее проверяют окраску: если урина стала ярко фиолетового цвета, тогда кислотность примерно 6, при окрашивании в серый оттенок нужно считать кислотность 7,2. Светло-фиолетовая моча указывает на уровень 6,6. Зеленая моча – это признак кислотности в 7,8.
Тест-полоски, применяемые как в большинстве лабораторий, так и в домашних условиях, при проведении самостоятельных проверок на уровень Ph. Их можно приобрести в аптеках и применять по мере необходимости.
Плюсом подобного исследования является простота, поскольку с определением кислотности в урине подобным способом может справиться любой человек. Полоску опускают в свежую порцию мочи, а затем смотрят результат по специальной шкале с обозначенной цветовой гаммой.
Отклонения результатов анализа мочи при беременности: причины, коррекция
Отклонения от нормы в общем анализе мочи во 2 и 3 триместре беременности часто не являются признаками заболевания, а обусловлены увеличившимся давлением на почки растущей матки, являются следствием особенностей питания, физической или эмоциональной нагрузки, а также несоблюдения правил сбора материала для исследования. Поэтому при получении результата, выходящего за пределы нормы, анализ проводится повторно. В ряде случаев назначаются дополнительные анализы мочи (анализ мочи по Нечипоренко, по Зимницкому, бактериологический посев мочи и пр.), крови и другие исследования.
Видео с YouTube по теме статьи:
Подготовка к сдаче мочи на кислотную среду
Самые объективные показатели получают при исследовании утренней мочи.
Перед её сбором необходимо провести гигиенические процедуры половых органов. Сдавать урину на анализ лучше в стерильных контейнерах, купленных в аптеке, не позже чем через 2 часа после сбора. Если срок хранения больше, то может произойти защелачивание или повышение кислотности.
Моча должна доставляться в лабораторию при температуре не ниже 10 °C. При более низких температурах, образуется осадок, что затрудняет исследование.
Перед сдачей мочи на анализ не рекомендуется:
- Минимум за 8 часов до исследования приём лекарственных препаратов, пищи.
- Физические нагрузки.
- Употребление жареной, копчённой, маринованной пищи.
- Употребление алкоголя, кофе, продуктов с содержанием пигмента, влияющего на цвет мочи.
На заметку! При повышенной температуре тела урина будет иметь кислую среду.
Как привести кислотность мочи в норму
Перед тем, как начать лечение и нормализовать показатель, необходимо диагностировать, что привело к отклонениям. Перед лечением обязательно проводится дополнительное обследование. Пациенту приписывается комплекс препаратов, направленных на избавление от основного заболевания. Дополнительно составляется диета, которая помогает нормализовать соотношение кислотной и щелочной среды.
Некоторые факторы устраняются изменением питания, оптимизацией физических нагрузок
Можно ли понизить кислотность мочи с помощью изменения рациона? Пища должна быть разнообразной, важно сократить потребление белков, а повысить количество употребляемых продуктов, имеющих отрицательное или нейтральное влияние на кислотно-щелочное соотношение
Разработан медицинский метод PRAL для расчета, с какой потенциальной нагрузкой могут работать почки. Он помогает оценить и оптимизировать количество употребляемого белка.
| Нулевой PRAL | Отрицательный PRAL |
|---|---|
|
|
Влияют на повышение кислотности продукты, считающиеся кислотосодержащими. При их переваривании концентрация кислот в выделениях увеличивается. Это сыры, мясные изделия, яйца, сахар, консервы, манка, цитрусовые фрукты. Их потребление нужно минимизировать. Основное правило диеты: 20% — кислотообразующих продуктов в рационе, 80% — щелочеобразующих.
Кислая моча часто диагностируется у людей с лишним весом. Тогда диета назначается не только с целью нормализовать pH, но и для общего снижения массы тела. Обязательно пить не менее 2-х литров чистой воды в день. Лучше, если это будет щелочная вода, обогащенная минералами – магнием, калием.
Расшифровка общего анализа мочи
Цвет, запах прозрачность
В норме моча прозрачная, имеет светло-желтый цвет и обычный (нерезкий) запах. Если цвет мочи напоминает темное пиво, это может быть признаком патологии печени и/или желчного пузыря. Ржавый цвет, мутность (так называемый вид мясных помоев) может означать поражение почек или других органов мочевыделительной системы. Мутный белесый цвет может говорить о повышенном количестве фосфатов. Моча может приобретать зеленовато-желтый цвет, что показывает наличие воспалительного процесса в почках. Помутнение мочи обычно указывает на то, что в ней присутствуют эпителий, лейкоциты, белок, являющиеся индикаторами воспаления мочевыделительных путей.
Кислотность (pH)
Повышение показателя кислотности (pH) происходит при хронической почечной недостаточности, повышении концентрации калия в крови, гиперфункции паращитовидных желез, инфекционно-воспалительных заболеваниях мочевыделительной системы, а также опухолевых поражениях мочеполовых путей. Кроме того, pH мочи повышается при соблюдении диеты с большим содержанием овощей и фруктов и пониженным – белка, длительной рвоте, метаболическом и дыхательном алкалозе.
Уровень pH ниже нормы может указывать на дефицит калия в организме, дегидратацию или патологии почек, сахарный диабет, метаболический и дыхательный ацидоз, лихорадку, голодание, соблюдении низкоуглеводной диеты.
Высокий уровень
Ощелачивание мочи – это состояние, при котором уровень ph значительно повышен. Спровоцировать такую проблему могут следующие факторы:
- Употребление чрезмерного количества щелочной минеральной воды.
- Длительное голодание.
- Повысить pH может введение в рацион избыточных порций растительной пищи.
- Длительные приступы рвоты. В результате этого из организма вымывается много ионов хлора, которые оказывают влияние на кислотность урины.
- Отклонения в работе надпочечников или щитовидной железы.
- Повышенная кислотность желудочного сока. Таким симптомом чаще сопровождается гиперацидный гастрит.
- Инфекционные заболевания мочевыделительной системы. Щелочная моча не отмечается только при заражении кишечной палочкой и бактерией туберкулеза. Остальные патогенные микроорганизмы значительно снижают уровень ph.
- Почечная недостаточность, перешедшая в хроническую стадию.
- Увеличивает Ph прогрессирующий гломерулонефрит.
- Почечный ацидоз.
- Употребление некоторых медикаментов. Оказать негативное воздействие могут препараты, содержащие адреналин и никотинамид.
Высокий уровень
Ощелачивание мочи – это состояние, при котором уровень ph значительно повышен. Спровоцировать такую проблему могут следующие факторы:
- Употребление чрезмерного количества щелочной минеральной воды.
- Длительное голодание.
- Повысить pH может введение в рацион избыточных порций растительной пищи.
- Длительные приступы рвоты. В результате этого из организма вымывается много ионов хлора, которые оказывают влияние на кислотность урины.
- Отклонения в работе надпочечников или щитовидной железы.
- Повышенная кислотность желудочного сока. Таким симптомом чаще сопровождается гиперацидный гастрит.
- Инфекционные заболевания мочевыделительной системы. Щелочная моча не отмечается только при заражении кишечной палочкой и бактерией туберкулеза. Остальные патогенные микроорганизмы значительно снижают уровень ph.
- Почечная недостаточность, перешедшая в хроническую стадию.
- Увеличивает Ph прогрессирующий гломерулонефрит.
- Почечный ацидоз.
- Употребление некоторых медикаментов. Оказать негативное воздействие могут препараты, содержащие адреналин и никотинамид.
Как правильно пользоваться
Чтобы выявить страдает ли человек глюкозурией, нужно провести определенные манипуляции с тестом-полоской.
Проверить мочу на сахар с помощью нее можно следующим образом:
- Моча должна быть собрана в стерильную ёмкость.
- Полоска достается из упаковки. В открытом состоянии она должна быть использована в течение суток.
- Полоска для проверки мочи на сахар опускается вниз той стороной, где есть реактивы.
- Необходимо подождать 60 секунд, после чего достать ее и сверить результат согласно инструкции.
Обратите внимание, моча не должна иметь сильного осадка, быть свежей (не старше 1-2 часов) и тщательно перемешанной. В здоровом состоянии в человеческой моче нет глюкозы или ее количество настолько незначительно, что никакие анализы и тестирование не указывают на ее наличие
В здоровом состоянии в человеческой моче нет глюкозы или ее количество настолько незначительно, что никакие анализы и тестирование не указывают на ее наличие.
Если после проверки вы получили положительный результат, следует немедленно обратиться к доктору и провести полное обследование.
Виды тест-полосок
На сегодняшний день изготовлением полосок для проведения тестов занимаются многие страны. В числе известных компаний можно назвать:
- российские – «Биоскан» и «Биосенор»;
- корейская – Uriscan;
- канадская – Multicheck;
- швейцарская – Mcral-Test;
- американская – UrineRS.

Любой изготовитель предоставляет обширный перечень наборов для диагностирования, помогающих проверить разнообразные параметры:
- глюкозу;
- кетоны;
- уровень кислотности;
- эритроциты, белок, лейкоциты, показатель плотности;
- уробилиноген, нитриты, креатинин, билирубин.
Сочетание индикатора из нескольких реагентных элементов на одном тесте дает возможность оптимизировать выполнение диагностирования, учитывая преследуемые цели. К примеру, для контроля уровня сахара при диабете, на тест-полоску наносится индикаторный элемент, реагирующий на глюкозу и кетоны. В случаях с симптоматикой на диабетическую нефропатию, рекомендуется воспользоваться полосками, совместившими в себе индикаторы:
- крови;
- белка;
- нитритов;
- глюкозы;
- кетонов.
Считается, что любой изготовитель производит тест-полоски, используемые не только при визуальных обследованиях, но и при инструментальных, когда применяются анализаторы.
Итоги
pH мочи – это цифровой показатель физико-химических реакций, отражающих состояние кислотно-щелочного баланса в организме. Измерение кислотности проводится в ходе общего анализа мочи и является важным диагностическим критерием. Оценка pH урины позволяет своевременно выявить нарушения обменных процессов, возможные сбои в работе почечного аппарата и других органов мочевыделительной системы.
Референсное значение кислотности составляет от 5 до 7 единиц. Различие значений утренней и вечерней мочи, не относится к патологиям, поскольку кислотно-щелочные реакции во многом зависят от употребляемых продуктов и напитков. Показатель 5 ед. (и ниже) свидетельствует о закислении урины. Семь и более единиц в результате анализа указывает на защелачивание.
Оба эти состояния являются анормальными. При сдвиге pH необходимо пройти дополнительное обследование для установления причины нарушения кислотно-щелочного равновесия. Для самостоятельного определения уровня кислотности мочи фармакологическая промышленность выпускает специальные экспресс-тесты в виде стрипов.


















































